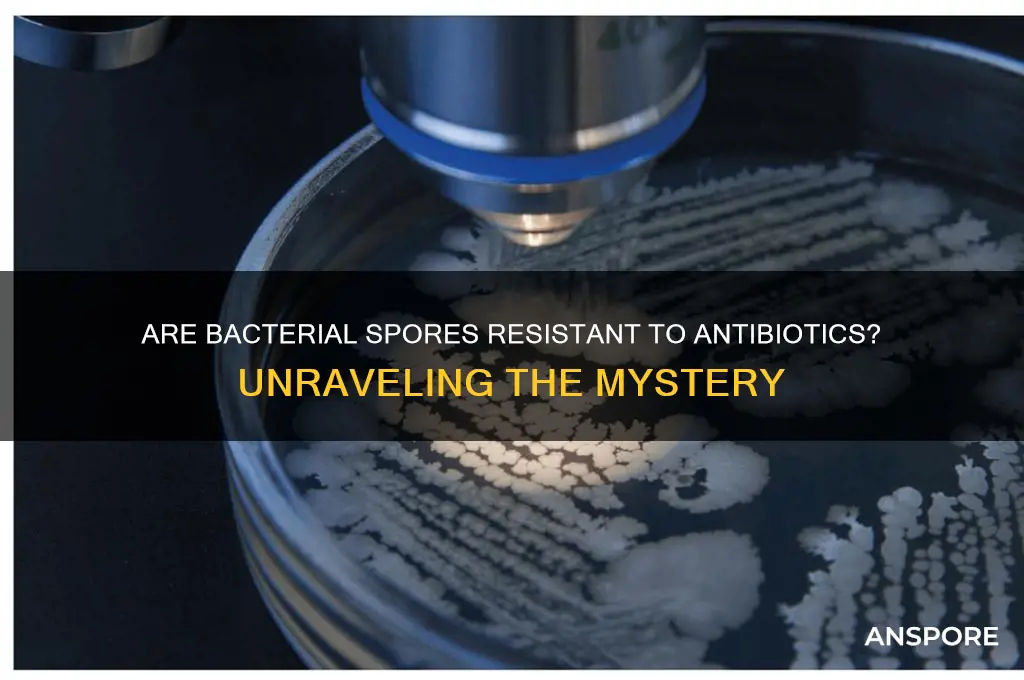
are bacterial spores resistant to antibiotics

Bacterial spores are highly resistant structures produced by certain bacteria, such as *Bacillus* and *Clostridium*, as a survival mechanism in harsh environments. Unlike vegetative bacterial cells, spores possess a thick, multi-layered protective coat and a dehydrated cytoplasm, which confer remarkable resistance to extreme conditions, including heat, radiation, and many chemicals. This resistance extends to antibiotics, as the dormant state of spores and their impermeable outer layers significantly reduce the efficacy of most antimicrobial agents. While antibiotics are effective against actively growing bacteria, they often fail to eradicate spores, necessitating specialized treatments like high-temperature sterilization or spore-specific antibiotics. Understanding the mechanisms behind spore resistance to antibiotics is crucial for developing strategies to combat spore-forming pathogens in medical, industrial, and environmental settings.
| Characteristics | Values |
|---|---|
| Resistance to Antibiotics | Bacterial spores are highly resistant to most antibiotics due to their dormant and protective structure. |
| Dormancy | Spores are metabolically inactive, making them less susceptible to antibiotics that target active cellular processes. |
| Spore Coat | The outer layer of the spore is composed of keratin-like proteins, providing a physical barrier against antibiotics and other environmental stressors. |
| Low Permeability | The spore coat and cortex have low permeability, preventing antibiotics from entering the spore. |
| DNA Protection | Spores contain a core with highly compacted and protected DNA, making it resistant to DNA-targeting antibiotics. |
| Antibiotics Ineffective Against Spores | Most antibiotics, including penicillins, cephalosporins, and many others, are ineffective against bacterial spores. |
| Effective Agents Against Spores | Only a few agents, such as heat, radiation, and specific chemicals (e.g., hydrogen peroxide, glutaraldehyde), can effectively kill spores. |
| Germination Requirement | Spores must germinate into vegetative cells before antibiotics can be effective, as antibiotics target active metabolic processes. |
| Clinical Relevance | Spore-forming bacteria like Clostridioides difficile and Bacillus anthracis pose challenges in treatment due to spore resistance. |
| Research Focus | Ongoing research aims to develop new antibiotics or strategies to target spores directly or prevent germination. |
Explore related products
What You'll Learn
- Spore Coat Structure: How the multi-layered spore coat acts as a physical barrier to antibiotics
- Dormant State Resistance: Spores' metabolic inactivity reduces antibiotic targets, increasing survival rates
- Germination Triggers: Antibiotic effectiveness depends on whether spores are in dormant or active states
- Antibiotic Penetration: Spores' low permeability limits antibiotic entry, reducing treatment efficacy
- Resistance Mechanisms: Spores may possess genetic traits enhancing resistance to multiple antibiotics

Spore Coat Structure: How the multi-layered spore coat acts as a physical barrier to antibiotics
Bacterial spores are renowned for their resilience, capable of withstanding extreme conditions that would destroy their vegetative counterparts. Central to this durability is the spore coat, a multi-layered structure that serves as a formidable physical barrier against antibiotics. Unlike the cell wall of vegetative bacteria, the spore coat is composed of multiple layers of proteins, peptides, and glycoproteins, each contributing to its protective function. This intricate architecture not only shields the spore’s genetic material but also limits the penetration of antimicrobial agents, making spores notoriously difficult to eradicate.
To understand how the spore coat resists antibiotics, consider its layered composition. The outermost layer, often rich in keratin-like proteins, acts as a primary defense against environmental stressors, including desiccation and heat. Beneath this lies a layer of peptidoglycan, modified to be more resilient than that found in vegetative cells. These layers are further reinforced by an inner coat composed of specialized proteins that provide additional structural integrity. Together, these layers create a dense, cross-linked matrix that impedes the diffusion of antibiotics, which often rely on size and charge to penetrate bacterial cells. For instance, large-molecule antibiotics like vancomycin struggle to traverse this barrier, rendering them ineffective against dormant spores.
The spore coat’s resistance is not merely passive; it is an active system designed to exclude foreign substances. Studies have shown that the coat’s hydrophobic nature repels many antibiotics, which are typically hydrophilic. Additionally, the coat’s low porosity restricts the entry of molecules larger than a few angstroms, effectively blocking most antimicrobial agents. This physical exclusion mechanism is particularly problematic in clinical settings, where bacterial spores like *Clostridioides difficile* and *Bacillus anthracis* can persist on surfaces and in tissues, evading standard antibiotic treatments. Even high doses of antibiotics, such as 10–20 mg/kg of amoxicillin, fail to eliminate spores due to this barrier.
Practical implications of the spore coat’s resistance are significant, especially in healthcare and food safety. For example, in hospitals, spore-forming bacteria can survive on surfaces for months, necessitating the use of sporicidal agents like hydrogen peroxide or chlorine dioxide for disinfection. In the food industry, spores of *Bacillus cereus* and *Clostridium botulinum* can withstand pasteurization temperatures, requiring more aggressive treatments like high-pressure processing or irradiation. Understanding the spore coat’s structure allows for the development of targeted strategies, such as combining antibiotics with coat-degrading enzymes or using nanoparticles to bypass the barrier.
In conclusion, the spore coat’s multi-layered structure is a masterclass in biological defense, providing a physical barrier that renders spores resistant to most antibiotics. Its complexity underscores the need for innovative approaches to combat spore-forming pathogens. By dissecting this structure, researchers can design more effective treatments, ensuring that even the most resilient bacterial forms are not beyond reach.
Mastering Spore Print Storage: Essential Tips for Long-Term Preservation
You may want to see also

Dormant State Resistance: Spores' metabolic inactivity reduces antibiotic targets, increasing survival rates
Bacterial spores, such as those produced by *Bacillus* and *Clostridium* species, are notorious for their resilience against antibiotics. This resistance is not due to genetic mutations or efflux pumps but rather to their dormant state, characterized by metabolic inactivity. When spores enter this quiescent phase, their internal processes slow to a near halt, drastically reducing the number of active targets that antibiotics rely on to exert their effects. For instance, antibiotics like penicillin target cell wall synthesis, a process that is virtually non-existent in dormant spores. This metabolic dormancy acts as a protective shield, rendering many antibiotics ineffective.
Consider the practical implications of this resistance mechanism. In healthcare settings, spore-forming bacteria like *Clostridioides difficile* pose significant challenges, especially in patients undergoing prolonged antibiotic treatment. The spores survive the initial antibiotic assault, only to germinate later when conditions are favorable, leading to recurrent infections. To combat this, clinicians often prescribe combination therapies, such as vancomycin (125 mg every 6 hours) or fidaxomicin (200 mg twice daily), which target both vegetative cells and spores. However, even these treatments are not foolproof, as spores’ metabolic inactivity limits their efficacy. Understanding this dormant state resistance is crucial for developing more effective strategies to eradicate spore-forming pathogens.
From an analytical perspective, the metabolic inactivity of spores creates a paradox for antibiotic development. Traditional antibiotics are designed to target active cellular processes, such as DNA replication, protein synthesis, or cell wall formation. Spores, however, bypass these vulnerabilities by shutting down these processes. This necessitates a shift in approach—rather than targeting metabolic pathways, researchers must explore alternative strategies, such as disrupting spore coat integrity or inhibiting germination mechanisms. For example, compounds like nisins or certain bacteriophages show promise by directly attacking spore structures, offering a potential workaround to dormant state resistance.
A comparative analysis highlights the stark difference between vegetative bacterial cells and spores. Vegetative cells, with their active metabolism, are susceptible to a wide range of antibiotics. Spores, on the other hand, require extreme measures, such as high-temperature sterilization (e.g., autoclaving at 121°C for 15–20 minutes) or prolonged exposure to harsh chemicals like bleach, to ensure their destruction. This comparison underscores the unique challenge posed by spores and the need for tailored solutions. For industries like food preservation or medical device sterilization, understanding this distinction is vital to implementing effective decontamination protocols.
Finally, a persuasive argument can be made for investing in research to overcome dormant state resistance. The rise of antibiotic-resistant infections, coupled with the persistence of spore-forming pathogens, threatens global health security. By focusing on spore-specific vulnerabilities, such as their reliance on germination triggers or their unique coat composition, scientists can develop novel antimicrobials that target these dormant forms. Public health initiatives should prioritize funding for such research, as breaking the resistance barrier of bacterial spores could revolutionize infection control and save countless lives. Practical steps include supporting interdisciplinary studies, fostering collaborations between microbiologists and material scientists, and promoting the development of spore-targeted therapies.
Mastering Morel Mushroom Propagation: Effective Techniques to Spread Spores
You may want to see also

Germination Triggers: Antibiotic effectiveness depends on whether spores are in dormant or active states
Bacterial spores, particularly those from genera like *Bacillus* and *Clostridium*, are renowned for their resilience against antibiotics. This resistance is not due to genetic mutations or acquired mechanisms but rather the spore’s dormant state, which renders it metabolically inactive. Antibiotics, designed to target active cellular processes such as DNA replication, protein synthesis, or cell wall formation, are ineffective against spores because these processes are halted during dormancy. However, the moment a spore germinates and transitions to its vegetative, metabolically active form, it becomes vulnerable to antibiotic attack. This critical shift underscores the importance of understanding germination triggers to enhance antibiotic effectiveness.
Germination is not a spontaneous event but a response to specific environmental cues. Nutrient availability, particularly amino acids like L-valine or glycine, is a primary trigger for many bacterial spores. For instance, *Bacillus subtilis* spores require these nutrients to initiate germination, a process that can be exploited in clinical settings. By controlling the nutrient environment, healthcare providers can manipulate the timing of spore activation. Once germinated, spores can be targeted with antibiotics such as penicillin or vancomycin, which disrupt cell wall synthesis in the actively growing vegetative cells. This strategy requires precise timing and knowledge of the spore’s specific triggers to ensure effectiveness.
Temperature and pH changes also act as germination triggers, though their impact varies by species. *Clostridioides difficile* spores, for example, are more likely to germinate in the slightly alkaline environment of the small intestine, a factor that contributes to their pathogenicity. In laboratory or clinical settings, adjusting temperature to 37°C (human body temperature) can induce germination in many spore-forming bacteria. However, this approach must be paired with immediate antibiotic administration to prevent the establishment of a vegetative population. Failure to act swiftly can result in antibiotic resistance, as spores revert to dormancy under stress, creating a recurring cycle of persistence.
Practical applications of germination-based strategies are emerging in medical and industrial contexts. For instance, in wound care, dressings infused with nutrient triggers can be used to activate spores before applying topical antibiotics like mupirocin. Similarly, in food preservation, controlled germination followed by heat or antibiotic treatment can eliminate spore contaminants. However, caution is necessary, as over-reliance on germination triggers may lead to unintended activation of spores in non-target environments. Balancing precision and practicality is key to leveraging this knowledge effectively.
In conclusion, the dormant-to-active transition of bacterial spores is a double-edged sword in antibiotic treatment. While dormancy confers resistance, germination exposes spores to antibiotic susceptibility. By identifying and manipulating specific triggers—nutrients, temperature, or pH—clinicians and researchers can optimize treatment protocols. This approach not only enhances antibiotic effectiveness but also minimizes the risk of spore persistence and recurrence. Understanding germination dynamics is thus essential for tackling the challenges posed by spore-forming bacteria in healthcare and beyond.
Extending Mushroom Spores Lifespan: Fridge Storage Tips and Duration
You may want to see also
Explore related products

Antibiotic Penetration: Spores' low permeability limits antibiotic entry, reducing treatment efficacy
Bacterial spores present a formidable challenge in antibiotic treatment due to their inherently low permeability, which significantly restricts the entry of antimicrobial agents. This structural feature is a key mechanism of resistance, as it effectively shields the spore’s genetic material and metabolic machinery from external threats. Unlike vegetative bacterial cells, which have more permeable membranes, spores are encased in multiple protective layers, including a thick peptidoglycan cortex and a proteinaceous coat. These layers act as a barrier, reducing the efficacy of antibiotics by limiting their ability to penetrate and reach their intracellular targets. For instance, common antibiotics like penicillin and erythromycin, which target cell wall synthesis or protein production, struggle to breach these defenses, rendering them largely ineffective against dormant spores.
To understand the implications of this low permeability, consider the treatment of spore-forming pathogens such as *Clostridioides difficile* or *Bacillus anthracis*. In clinical settings, standard antibiotic regimens often fail to eradicate these organisms completely because the spores remain unaffected. Even high dosages, such as 500 mg of metronidazole every 8 hours for *C. difficile*, may not achieve sufficient intracellular concentrations to kill spores. This persistence can lead to recurrent infections, as spores germinate into vegetative cells once the antibiotic pressure is removed. The challenge is further compounded by the fact that spores can remain dormant for years, waiting for favorable conditions to reactivate, making them a persistent threat in healthcare and environmental settings.
Addressing this issue requires a strategic approach. One method is to combine antibiotics with spore-germination inducers, such as calcium dipicolinate or specific nutrients, to coax spores into their more vulnerable vegetative state. For example, in treating *B. anthracis* infections, ciprofloxacin (400 mg IV every 12 hours) is often paired with adjuvant therapies to ensure spores germinate and become susceptible to the antibiotic. Another strategy involves using antibiotics with enhanced penetration capabilities, such as rifampin or vancomycin, though their efficacy is still limited by the spore’s robust structure. Practical tips for healthcare providers include ensuring prolonged treatment durations (e.g., 10–14 days for *C. difficile*) and monitoring for recurrence, as spores may survive initial therapy.
Comparatively, the low permeability of spores contrasts sharply with the susceptibility of vegetative cells, highlighting the need for targeted interventions. While vegetative cells can be effectively treated with standard antibiotic regimens, spores demand a more nuanced approach. Research into novel antimicrobial agents, such as spore-specific peptidoglycan inhibitors or coat-degrading enzymes, holds promise for overcoming this barrier. Until such advancements become widely available, clinicians must rely on combination therapies and extended treatment protocols to manage spore-forming infections effectively.
In conclusion, the low permeability of bacterial spores is a critical factor in their resistance to antibiotics, necessitating tailored treatment strategies. By understanding the structural and functional barriers posed by spores, healthcare providers can optimize therapy, reduce recurrence rates, and improve patient outcomes. Practical measures, such as combining antibiotics with germination inducers and extending treatment durations, are essential steps in combating these resilient organisms. As research progresses, innovative solutions may further enhance our ability to penetrate spore defenses, offering hope for more effective treatments in the future.
Can Heat Kill Mold Spores? Effective Temperatures and Methods Explained
You may want to see also

Resistance Mechanisms: Spores may possess genetic traits enhancing resistance to multiple antibiotics
Bacterial spores, particularly those of species like *Clostridioides difficile* and *Bacillus anthracis*, are notorious for their inherent resistance to antibiotics. This resilience is not merely a passive trait but an active defense mechanism rooted in their genetic makeup. Spores harbor genes that encode for multidrug efflux pumps, enzymes capable of modifying or degrading antibiotics, and thickened cell walls that impede drug penetration. For instance, the *B. subtilis* spore’s outer coat contains keratin-like proteins that act as a physical barrier, reducing antibiotic efficacy by up to 90% compared to their vegetative counterparts. Understanding these genetic traits is critical for developing targeted therapies that can bypass or neutralize these defenses.
One of the most striking resistance mechanisms is the spore’s ability to remain dormant under antibiotic exposure. Unlike actively replicating cells, spores are metabolically inactive, rendering many antibiotics ineffective since these drugs typically target processes like DNA replication or protein synthesis. For example, beta-lactam antibiotics, which inhibit cell wall synthesis, are largely ineffective against spores because their cell wall is pre-formed and highly resistant to degradation. This dormancy-based resistance necessitates the use of spore-specific treatments, such as high-temperature sterilization or spore-activating agents like germinants, to force spores into a vegetative state where antibiotics can act.
Genetic analysis has revealed that spores often carry plasmids or chromosomal genes conferring resistance to multiple antibiotic classes. For instance, *C. difficile* spores frequently harbor genes for resistance to fluoroquinolones and clindamycin, complicating treatment of infections. These resistance genes can be horizontally transferred between bacteria, exacerbating the spread of multidrug-resistant strains. Clinicians must therefore exercise caution when prescribing broad-spectrum antibiotics, as their overuse can inadvertently select for resistant spore-forming bacteria. Rotating antibiotic classes or combining them with spore-targeting agents may mitigate this risk.
Practical strategies to combat spore resistance include optimizing antibiotic dosage and duration. For example, vancomycin, a glycopeptide antibiotic, is often administered at higher doses (e.g., 125 mg every 6 hours) to treat *C. difficile* infections, but even this may fail against mature spores. Pairing antibiotics with physical methods like heat treatment or UV light can enhance efficacy by weakening the spore’s outer layers. Additionally, emerging research into spore germination inhibitors, such as those targeting the germinant receptor proteins, offers a promising avenue for preventing spore activation and subsequent infection.
In conclusion, the genetic traits of bacterial spores provide a multifaceted shield against antibiotics, necessitating a nuanced approach to treatment. By understanding these mechanisms—from dormancy-based resistance to multidrug efflux systems—clinicians and researchers can devise more effective strategies. Combining traditional antibiotics with innovative spore-targeting methods may hold the key to overcoming this formidable challenge in infectious disease management.
Best Places to Buy Spores: A Comprehensive Guide for Enthusiasts
You may want to see also
Frequently asked questions
Yes, bacterial spores are highly resistant to antibiotics. Their dormant, protective structure allows them to survive harsh conditions, including exposure to many antibiotics.
Bacterial spores have a thick, impermeable outer layer and low metabolic activity, which makes it difficult for antibiotics to penetrate and target their cellular processes.
Most antibiotics are ineffective against spores. However, once spores germinate into active bacteria, they become susceptible to antibiotics.
Bacterial spores can be eliminated through methods like heat (autoclaving), strong chemicals (disinfectants), or radiation, as these methods physically destroy the spore structure.


















![Substances screened for ability to reduce thermal resistance of bacterial spores 1959 [Hardcover]](https://m.media-amazon.com/images/I/51Z99EgARVL._AC_UL320_.jpg)






